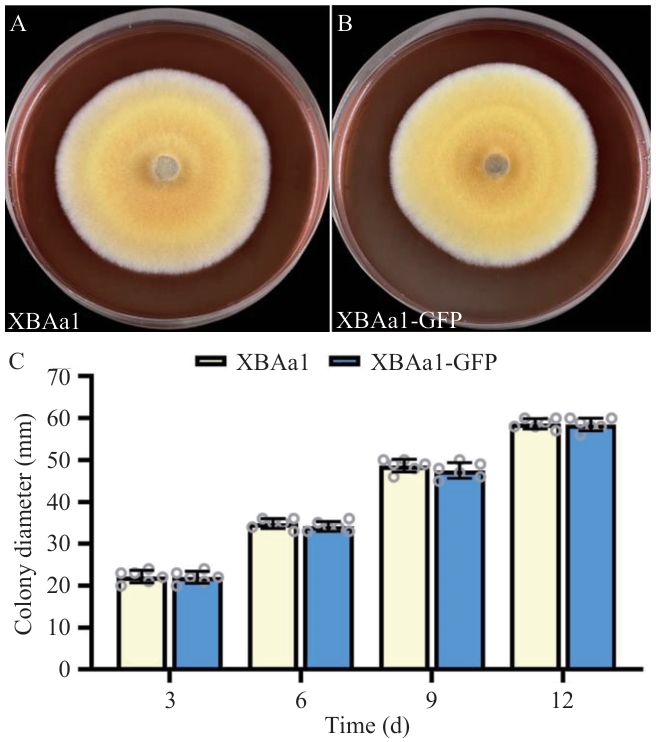

Biotechnology Bulletin ›› 2026, Vol. 42 ›› Issue (4): 321-331.doi: 10.13560/j.cnki.biotech.bull.1985.2025-0732
Previous Articles Next Articles
GENG Ming-yan1( ), FENG Hui1, HE Lei2, ZHANG Guo-zheng1, WANG Jing1(
), FENG Hui1, HE Lei2, ZHANG Guo-zheng1, WANG Jing1( )
)
Received:2025-07-07
Online:2026-04-26
Published:2026-04-30
Contact:
WANG Jing
E-mail:gengmingyan_xy@qq.com;wangjing06@caas.cn
GENG Ming-yan, FENG Hui, HE Lei, ZHANG Guo-zheng, WANG Jing. Growth-promoting Effect of Arcopilus aureus XBAa1 on Tobacco and Its Colonization in Tobacco Root[J]. Biotechnology Bulletin, 2026, 42(4): 321-331.

Fig. 2 Promoting effects of XBAa1 on early growth of tobacco under tissue culture and sterile substrate conditionsA, B: Tobacco-XBAa1 symbiosis in tissue culture. C, D, E, F: Above ground and root of the tobacco-XBAa1 symbiosis in the greenhouse. G: Root weight. H: Shoot weight (* P<0.05, **P<0.01, ***P<0.001, the same below)
Fig. 7 Colony characteristics of tagged strain XBAa1-GFP and wild type strain XBAa1A: Wild type XBAa1. B: XBAa1-GFP strain. C: Growth rates of strains
| [1] | Ye L, Zhao X, Bao EC, et al. Bio-organic fertilizer with reduced rates of chemical fertilization improves soil fertility and enhances tomato yield and quality [J]. Sci Rep, 2020, 10: 177. |
| [2] | Chowdhary K, Kaushik N. Fungal endophyte diversity and bioactivity in the Indian medicinal plant Ocimum sanctum linn [J]. PLoS One, 2015, 10(11): e0141444. |
| [3] | Gupta S, Schillaci M, Walker R, et al. Alleviation of salinity stress in plants by endophytic plant-fungal symbiosis: Current knowledge, perspectives and future directions [J]. Plant Soil, 2021, 461(1): 219-244. |
| [4] | Khan AL, Hamayun M, Kim YH, et al. Gibberellins producing endophytic Aspergillus fumigatus sp. LH02 influenced endogenous phytohormonal levels, isoflavonoids production and plant growth in salinity stress [J]. Process Biochem, 2011, 46(2): 440-447. |
| [5] | Turbat A, Rakk D, Vigneshwari A, et al. Characterization of the plant growth-promoting activities of endophytic fungi isolated from Sophora flavescens . [J]. Microorganisms, 2020, 8(5): 683. |
| [6] | García-Latorre C, Rodrigo S, Marin-Felix Y, et al. Plant-growth promoting activity of three fungal endophytes isolated from plants living in dehesas and their effect on Lolium multiflorum . [J]. Sci Rep, 2023, 13: 7354. |
| [7] | Wang XW, Houbraken J, Groenewald JZ, et al. Diversity and taxonomy of Chaetomium and Chaetomium-like fungi from indoor environments [J]. Stud Mycol, 2016, 84: 145-224. |
| [8] | Amaral De Faria Silva L, Ferreira Alves M, Florêncio Filho D, et al. Pigment produced from Arcopilus aureus isolated from grapevines: Promising natural yellow colorants for the food industry [J]. Food Chem, 2022, 389: 132967. |
| [9] | Da Silva Júnior FMR, Volcão LM, Hoscha LC, et al. Growth of the fungus Chaetomium aureum in the presence of lead: implications in bioremediation [J]. Environ Earth Sci, 2018, 77(7): 275. |
| [10] | 刘永亮, 尹成林, 田叶韩, 等. 拮抗真菌HTC的鉴定及其对辣椒疫病的生物防治潜力 [J]. 植物保护学报, 2013, 40(5): 437-444. |
| Liu YL, Yin CL, Tian YH, et al. Identification of the antagonistic fungus strain HTC and its potential for biocontrol of pepper Phytophthora blight [J]. J Plant Prot, 2013, 40(5): 437-444. | |
| [11] | Wang YL, Liu SY, Mao XQ, et al. Identification and characterization of rhizosphere fungal strain MF-91 antagonistic to rice blast and sheath blight pathogens [J]. J Appl Microbiol, 2013, 114(5): 1480-1490. |
| [12] | 陈楠, 于飞, 何艳柳, 等. 一株水稻促生长内生真菌的绿色荧光蛋白基因标记与示踪 [J]. 生物技术通报, 2017, 33(3): 100-105. |
| Chen N, Yu F, He YL, et al. Labeling and tracing of green fluorescent protein in fungal endophyte with growth-promoting activity to rice seedlings [J]. Biotechnol Bull, 2017, 33(3): 100-105. | |
| [13] | 闫思远, 杜娟, 杨富龙, 等. PEG介导枸杞内生真菌NQ8GⅡ4遗传转化及转化子评价 [J]. 园艺学报, 2020, 47(12): 2385-2396. |
| Yan SY, Du J, Yang FL, et al. Establishment of genetic transformation system of lycium barbarum endophytic fungus fusarium nematophilum NQ8GⅡ4 using PEG-mediated method and transformants evaluation [J]. Acta Hortic Sin, 2020, 47(12): 2385-2396. | |
| [14] | Kaur N, Arora DS, Kalia N, et al. Bioactive potential of endophytic fungus Chaetomium globosum and GC-MS analysis of its responsible components [J]. Sci Rep, 2020, 10: 18792. |
| [15] | Ren CL, Li SY, Li PP, et al. Pathogen-activated Chaetomium globosum G3 enhances iron competition and other antagonistic mechanisms to suppress maize seedling blight causal agent Fusarium verticillioides [J]. Microbiol Res, 2025, 298: 128237. |
| [16] | 李梅, 辛平, 杨谦. 球毛壳菌原生质体形成与再生研究 [J]. 哈尔滨工业大学学报, 2002(5): 595-598. |
| Li M, Xin P, Yang Q. Formation and regeneration of protoplasts of chaetomium globosum [J]. J Harbin Inst Technol, 2002(5): 595-598. | |
| [17] | 耿铭言. 内生真菌Arcopilus aureus XBAa1对烟草抗黑胫病的影响及其应用研究 [D]. 北京: 中国农业科学院, 2024. |
| Geng MY. Study on influence of enocophytic fungus arcopilus aureus XBAa1 to tobacco black shank and its application [D]. Beijing: Chinese Academy of Agricultural Sciences, 2024. | |
| [18] | 龚一富. 植物组织培养实验指导 [M]. 北京: 科学出版社, 2011. |
| Gong YF. Guidance for plant tissue culture experiment [M]. Beijing: Science Press, 2011. | |
| [19] | 方中达. 植病研究方法(第三版)[M]. 北京:中国农业出版社,1998. |
| Fang ZD. Research method in plant pathology (3ird edition) [M]. Beijing: China Agriculture Press, 1998. | |
| [20] | Joseph KK, Elias NKS, Benjamin KB. Morphological and molecular characterisation of Colletotrichum gloeosporioides (Penz) isolates obtained from Dioscorea rotundata (Poir) [J]. Afr J Biotechnol, 2020, 19(5): 231-239. |
| [21] | 王晓琳. 氮素水平对烟草幼苗叶片光合特性的影响[M]. 北京:中国农业科学院,2019 |
| Wang XL. The effects of nitrogen supply on photosynthetic characteristics in leaves of tobacco seedlings [M]. Beijing: Chinese Academy of Agricultural Sciences, 2019 | |
| [22] | 王晓云, 李向东, 邹琦, 等. 施氮对花生叶片多胺代谢及衰老的调控作用 [J]. 作物学报, 2001, 27(4): 442-446. |
| Wang XY, Li XD, Zou Q, et al. Regulation effects of nitrogen application on the polyamine metabolism and senescence of peanut leaves [J]. Acta Agron Sin, 2001, 27(4): 442-446. | |
| [23] | Pan XQ, Welti R, Wang XM. Quantitative analysis of major plant hormones in crude plant extracts by high-performance liquid chromatography-mass spectrometry [J]. Nat Protoc, 2010, 5(6): 986-992. |
| [24] | 叶丽丹. 球毛壳菌与绿色木霉的荧光标记及生防特性研究 [D]. 杭州: 浙江大学, 2006. |
| Ye LD. Gfp-labeling and bioconl and analysis of Chaetomium globosum and Trichoderma viride[D]. Hangzhou: Zhejiang University, 2006. | |
| [25] | Zou G, Xiao ML, Chai SX, et al. Efficient genome editing in filamentous fungi via an improved CRISPR-Cas9 ribonucleoprotein method facilitated by chemical reagents [J]. Microb Biotechnol, 2021, 14(6): 2343-2355. |
| [26] | Winton LM, Stone JK, Watrud LS, et al. Simultaneous one-tube quantification of host and pathogen DNA with real-time polymerase chain reaction [J]. Phytopathology® , 2002, 92(1): 112-116. |
| [27] | Poveda J, Eugui D, Abril-Urías P, et al. Endophytic fungi as direct plant growth promoters for sustainable agricultural production [J]. Symbiosis, 2021, 85(1): 1-19. |
| [28] | Sytar O, Kumari P, Yadav S, et al. Phytohormone priming: regulator for heavy metal stress in plants [J]. J Plant Growth Regul, 2019, 38(2): 739-752. |
| [29] | 方治国, 杨青, 谢俊婷, 等. 重金属污染土壤植物修复中细胞分裂素的作用与机制 [J]. 生态学报, 2022, 42(8): 3056-3065. |
| Fang ZG, Yang Q, Xie JT, et al. The role and mechanism of cytokinin in phytoremediation of heavy metal contaminated soil [J]. Acta Ecol Sin, 2022, 42(8): 3056-3065. | |
| [30] | 李旭锐, 胡雪芳, 孙昊, 等. 黄龙疫苗(HB-1)对番茄苗期生理特性和病害防治效果的初步研究 [J]. 中国农学通报, 2021, 37(7): 100-105. |
| Li XR, Hu XF, Sun H, et al. Preliminary study on physiological characteristics and disease control effect of Huanglong vaccine (HB-1) in tomato seedling stage [J]. Chin Agric Sci Bull, 2021, 37(7): 100-105. | |
| [31] | Bae YS, Knudsen GR. Cotransformation of Trichoderma harzianum with β-glucuronidase and green fluorescent protein genes provides a useful tool for monitoring fungal growth and activity in natural soils [J]. Appl Environ Microbiol, 2000, 66(2): 810-815. |
| [32] | He MT, Tian ZY, Liu QQ, et al. Trichoderma asperellum promotes cadmium accumulation within maize seedlings [J]. Biotechnol Biotechnol Equip, 2021, 35(1): 1546-1559. |
| [33] | 郝晓冉, 纪元, 陈煌, 等. 纤维素降解球毛壳菌NK-102的高效遗传转化方法 [J]. 微生物学报, 2011(11): 1494-1501. |
| Hao XR, Ji Y, Chen H, et al. Two optimized transformation protocols for a cellulose-utilizing fungus Chaetomium globosum NK-102 [J]. Acta Microbiologica Sinica, 2011(11): 1494-1501. | |
| [34] | 刘建华. 里西裸囊菌杀线虫活性物质的分离鉴定与高效工程菌株的构建 [D]. 沈阳:沈阳农业大学,2012. |
| Liu JH. Isolation and identification of nematicidal compound and efficient construction of engineered strains of Gymnoascus reesii [D]. Shenyang: Shenyang Agricultural University, 2012. | |
| [35] | 肖荣凤, 朱育菁, 李燕丹, 等. 西瓜尖孢镰刀菌FOV-135的绿色荧光蛋白基因转化 [J]. 福建农业学报, 2009, 24(6): 521-524. |
| Xiao RF, Zhu YJ, Li YD, et al. Green fluorescent protein gene transformation on Fusarium oxysporum f. sp. niveum strain FOV-135 [J]. Fujian J Agric Sci, 2009, 24(6): 521-524. | |
| [36] | 叶丽丹, 劳佳萍, 卢建平, 等. 球毛壳菌荧光标记与重寄生现象研究 [J]. 浙江大学学报: 农业与生命科学版, 2007, 33(2): 119-124. |
| Ye LD, Lao JP, Lu JP, et al. Study on GFP-labeling and mycoparasitism in Chaetomium globosum [J]. J Zhejiang Univ Agric Life Sci, 2007, 33(2): 119-124. | |
| [37] | 李金, 闫思远, 陈思杰, 等. 枸杞内生真菌NQ8GⅡ4定殖促生作用研究 [J]. 西北农业学报, 2023, 32(3): 479-487. |
| Li J, Yan SY, Chen SJ, et al. Colonization and growth-promotion of endophytic fungus NQ8GⅡ4 of Chinese wolfberry [J]. Acta Agric Boreali Occidentalis Sin, 2023, 32(3): 479-487. | |
| [38] | Kim TG, Knudsen GR. Quantitative real-time PCR effectively detects and quantifies colonization of Sclerotia of Sclerotinia sclerotiorum by Trichoderma spp [J]. Appl Soil Ecol, 2008, 40(1): 100-108. |
| [39] | Alkan N, Gadkar V, Coburn J, et al. Quantification of the arbuscular mycorrhizal fungus Glomus intraradices in host tissue using real-time polymerase chain reaction [J]. New Phytol, 2004, 161(3): 877-885. |
| [40] | Stummer BE, Zhang Q, Zhang X, et al. Quantification of Trichoderma afroharzianum, Trichoderma harzianum and Trichoderma gamsii inoculants in soil, the wheat rhizosphere and in planta suppression of the crown rot pathogen Fusarium pseudograminearum . [J]. J Appl Microbiol, 2020, 129(4): 971-990. |
| [1] | ZHU Shan-shan, XU Jun, PAN Xing-lu, DONG Feng-shou, ZHENG Yong-quan, WU Xiao-hu. Research Advances in Microbial Remediation of Soil Pesticide Residues [J]. Biotechnology Bulletin, 2025, 41(12): 40-49. |
| [2] | WANG Jia-wei, LI Chen, LIU Jian-li, ZHOU Shi-jie, YI Jia-min, YANG Jin-yuan, KANG Peng. Effects of Endophytic Fungal Inoculation on the Seedling Growth of Silage Maize [J]. Biotechnology Bulletin, 2024, 40(4): 189-202. |
| [3] | PAN Guo-qiang, WU Si-yuan, LIU Lu, GUO Hui-ming, CHENG Hong-mei, SU Xiao-feng. Construction and Preliminary Analysis of Verticillim dahliae Mutant Library [J]. Biotechnology Bulletin, 2023, 39(5): 112-119. |
| [4] | YI Xi, LIAO Hong-dong, ZHENG Jing-yuan. Research Progress in Plant Endophytic Fungi for Root-knot Nematode Control [J]. Biotechnology Bulletin, 2023, 39(3): 43-51. |
| [5] | ZHANG Lin-lin, SHEN Hu-sheng, YANG Bing, HE Meng-han, PIAO Feng-zhi, SHEN Shun-shan. Control Ability and Identification of Biocontrol Agent HK11-9 Against Corynespora Leaf Spot of Cucumber [J]. Biotechnology Bulletin, 2023, 39(12): 209-218. |
| [6] | XU Jun, YE Yu-qing, NIU Ya-jing, HUANG He, ZHANG Meng-meng. Transcriptome Analysis of Rhizome Development in Chrysanthemum× × morifolium [J]. Biotechnology Bulletin, 2023, 39(10): 231-245. |
| [7] | LI Ying, LONG Chang-mei, JIANG Biao, HAN Li-zhen. Colonization on the Peanuts of Two Plant-growth Promoting Rhizobacteria Strains and Effects on the Bacterial Community Structure of Rhizosphere [J]. Biotechnology Bulletin, 2022, 38(9): 237-247. |
| [8] | TANG Guang-fu, GUI Yan-ling, MAN Hai-qiao, ZHAO Jie-hong. Editing pyrG Gene of Monascus by CRISPR/Cas 9 and Its Effects on Secondary Metabolism [J]. Biotechnology Bulletin, 2022, 38(8): 198-205. |
| [9] | SHI Jia, ZHU Xiu-mei, XUE Meng-yu, YU Chao, WEI Yi-ming, YANG Feng-huan, CHEN Hua-min. Optimization and Application of the Chromatin Immunoprecipitation Based on Rice Protoplast [J]. Biotechnology Bulletin, 2022, 38(7): 62-69. |
| [10] | GAO Xiao-ning, LIU Rui, WU Zi-lin, WU Jia-yun. Characteristics of Endophytic Fungal and Bacterial Community in the Stalks of Sugarcane Cultivars Resistant to Ratoon Stunting Disease [J]. Biotechnology Bulletin, 2022, 38(6): 166-173. |
| [11] | LI Si-si, ZHANG Bo-yuan, FU Yun-hui, ZHOU Jia, QU Jian-hang. Condition Optimization of an Efficient Phosphate-dissolving Bacterial Strain and Its Phosphate-dissolving Characteristics [J]. Biotechnology Bulletin, 2022, 38(12): 274-286. |
| [12] | ZHANG Shu-hua, FANG Qian, JIA Hong-mei, HAN Gui-qi, YAN Zhu-yun, HE Dong-mei. Difference Analysis of Fungal Community Among Bulk Soil,Rhizosphere and Rhizomes of Ligusticum chuanxiong Hort. [J]. Biotechnology Bulletin, 2021, 37(4): 56-69. |
| [13] | LI E, HUANG Yong, MENG Yuan-yuan, LI Xuan, DU Guang-hui, LIU Fei-hu. Isolation and Identification of the Endophytic Fungi of‘Bama hemp’ Under Salt Stress and Its Diversity Analysis [J]. Biotechnology Bulletin, 2021, 37(10): 26-33. |
| [14] | WANG Wei-xiong, SHEN Bo, JIA Hong-bai, QIAO Jun-qing, NIU Ben. Application of Rhizospheric Biocontrol Consortia and the Potential Mechanisms of Their Enhancing Efficacy on Disease-suppressive Effect [J]. Biotechnology Bulletin, 2020, 36(9): 31-41. |
| [15] | PAN Feng, HOU Kai, LIU Yun, WU Wei. Review for Research on Polysaccharides Produced by Endophytic Fungi Derived from Plants [J]. Biotechnology Bulletin, 2020, 36(7): 158-169. |
| Viewed | ||||||
|
Full text |
|
|||||
|
Abstract |
|
|||||